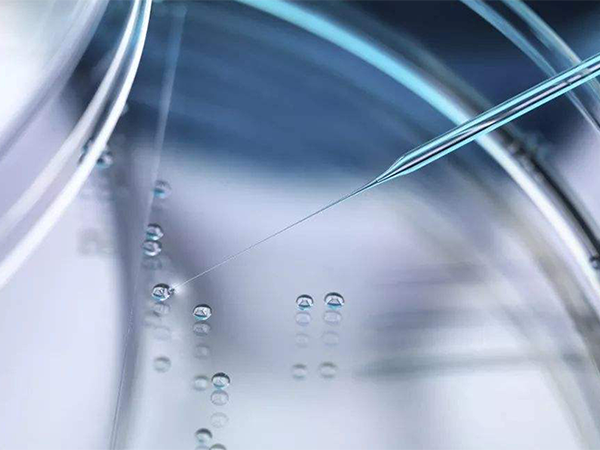

上海醫學中心
依使用者真實經歷、反饋整理上海國際醫學中心生殖中心成功率資料參考,綜合疾病、方案、需求等多維度彙總上海醫學中心試管嬰兒專家擅長,同步更新上海醫學中心生殖醫生成功率實時排名,幫助更多人發現上海醫學中心試管嬰兒專家誰最好。

上海醫學中心簡介,是否為公立醫保定點機構看完明白
根據網上公佈的資訊來看,上海國際醫學中心並不是三甲公立定點醫院。但其早在2013年的時候就與8家知名的三甲醫院成為了戰略合作伙伴,即很多三甲醫院的醫生會來到上海國際醫學中心進行會診,使該院診療服務的質量大大提高。且其還是上海社會辦醫療保險定點醫療機構之一,拿著上海的醫保卡可前往就醫。上海醫學中心的相關簡介上海國際醫學中心不是三甲公立醫院,是一家參與了疊加式醫保試點的私立醫院,也是上海首批高水平社會...

名偵探柯南
07-07
上海醫學中心試管技術如何?看完費用、成功率心下了然
上海國際醫學中心是一所大型綜合性醫院,裡面包括了內科、外科、婦產科、眼科、口腔科以及醫療美容和生殖中心等多個科室,其中上海國際醫學生殖中心於2019年正式執行,目前已經開展了男女不孕不育診斷和治療、人工授精、一二代試管嬰兒以及精子和胚胎的冷凍儲存等輔助生殖技術,並且上海醫學中心的試管技術非常不錯,很靠譜。上海醫學中心的試管技術上海國際醫學中心的試管嬰兒技術還是很靠譜的,它主要是由國際醫學中心和湖南...

趙素影
07-04
上海醫學中心試管成功率解析,全力聽從醫生安排機會更大
上海國際醫學中心試管成功率大概是在50%左右,目前該院針對於複發性流產、高齡、低反應、反覆植入失敗的治療有著豐富的經驗,符合以上條件的不孕患者選擇在上海國際醫學中心做試管嬰兒,治療期間的成功率還會更高一些。 上海醫學中心的試管嬰兒成功率上海國際醫學中心生殖醫學中心與湖南中信湘雅生殖與遺傳專科醫院強強聯合,而湖南中信湘雅生殖與遺傳專科醫院是國內做試管嬰兒比較好的私立醫療機構,所以這也不難看出上海國際...

猴皮筋
07-01








